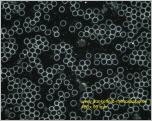
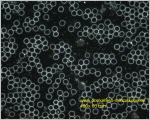

Vitalblutdiagnostik
Prävention - Vorsoge treffen
Für eine vorsorgende Blutdiagnostik ist es also sinnvoll, mehrere Blutuntersuchungsverfahren durchzuführen, die sich in diesem Sinne ergänzen:
Die klassische Labordiagnostik (Blutlabor mit Leberwerte, Nierenwerte …..) mit einem oder mehreren ganzheitlichen Bluttestverfahren zu anzubieten
Vitalblut - Dunkelfeld- Mikroskopie
Begründer dieser Diagnose und Therapieform war Prof. Dr. Enderlein (1872-1968) Die mikrobiologis...
Dried layer Rots Test
Kapillarblut ( ein aus der Fingerbeere entnommener Blutstropfen) wird auf einen Objektträger getu...
Meridian - Bluttest
Dieses mit Kapillarblut gewonnene Präventiv-Testverfahren bringt eine Aufschlüsselung unseres Ene...